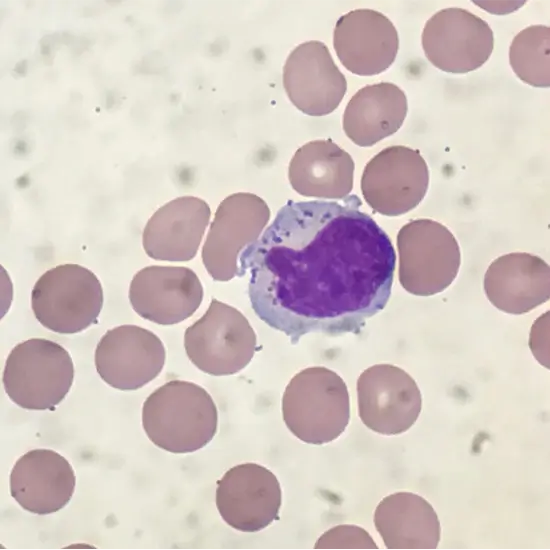

Book Natural Killer Cells Appointment Online Near me at the best price in Delhi/NCR from Ganesh Diagnostic. NABL & NABH Accredited Diagnostic centre and Pathology lab in Delhi offering a wide range of Radiology & Pathology tests. Get Free Ambulance & Free Home Sample collection. 24X7 Hour Open. Call Now at 011-47-444-444 to Book your Natural Killer Cells at 20% Discount.
Natural killer cells are part of the body's immune system in our bodies. They fight off infections and keep the body healthy. Blood tests are used to determine how many Natural Killer cells, or NK cells, are in your body.
A fertility doctor usually recommends this test if a woman has had a lot of miscarriages, two miscarriages after the age of 35, or a lot of IVF failures. NK cells that live in the uterus are called uNK, and they play an essential role in pregnancy. Some people can have too many or too few uNK cells, making it hard to get pregnant or have a miscarriage.
The number of NK cells can be found in this simple blood test. When a woman is going through her period, this test can be done at any time.
You'll have blood extracted from an arm vein.
No preparation is needed.
No particular type of care is required.
The Natural Killer Cell Test cost varies INR 2400 to INR 5000 by region and facility. So constantly get tested at trustworthy diagnostic centres like Ganesh Diagnostic. It is staffed by trained and experienced professionals to assure patient and visitor safety.
| Test Type | Natural Killer Cells |
| Includes | Natural Killer Cells Test (Hormones) |
| Preparation | |
| Reporting | Within 24 hours* |
| Test Price |
₹ 3000
|

Early check ups are always better than delayed ones. Safety, precaution & care is depicted from the several health checkups. Here, we present simple & comprehensive health packages for any kind of testing to ensure the early prescribed treatment to safeguard your health.